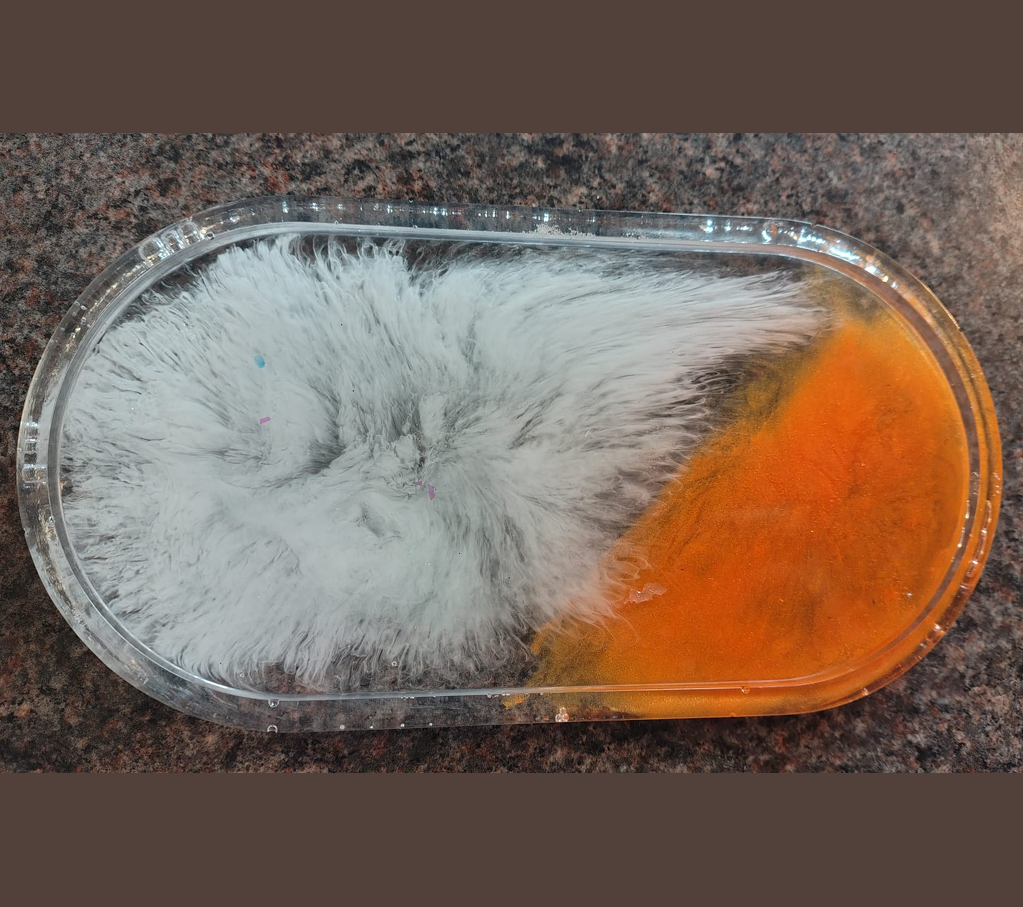

Description
-
Hand-poured resin trays and trinket boxes with a smooth, glossy finish
-
Unique swirls, shimmer, dried flowers, or custom colour themes — each piece is one-of-a-kind
-
Perfect for storing jewellery, keys, crystals, keepsakes, coins, or small accessories
-
Doubles as a decorative accent for desks, vanity counters, shelves, and entryway tables
-
Durable, lightweight, and easy to clean
-
Customisable with glitter, florals, initials, names, or themed colour combinations
-
Ideal for gifting on birthdays, anniversaries, festivals, housewarmings, or special occasions
-
A functional yet artistic keepsake that enhances both organisation and décor

Reviews
There are no reviews yet.